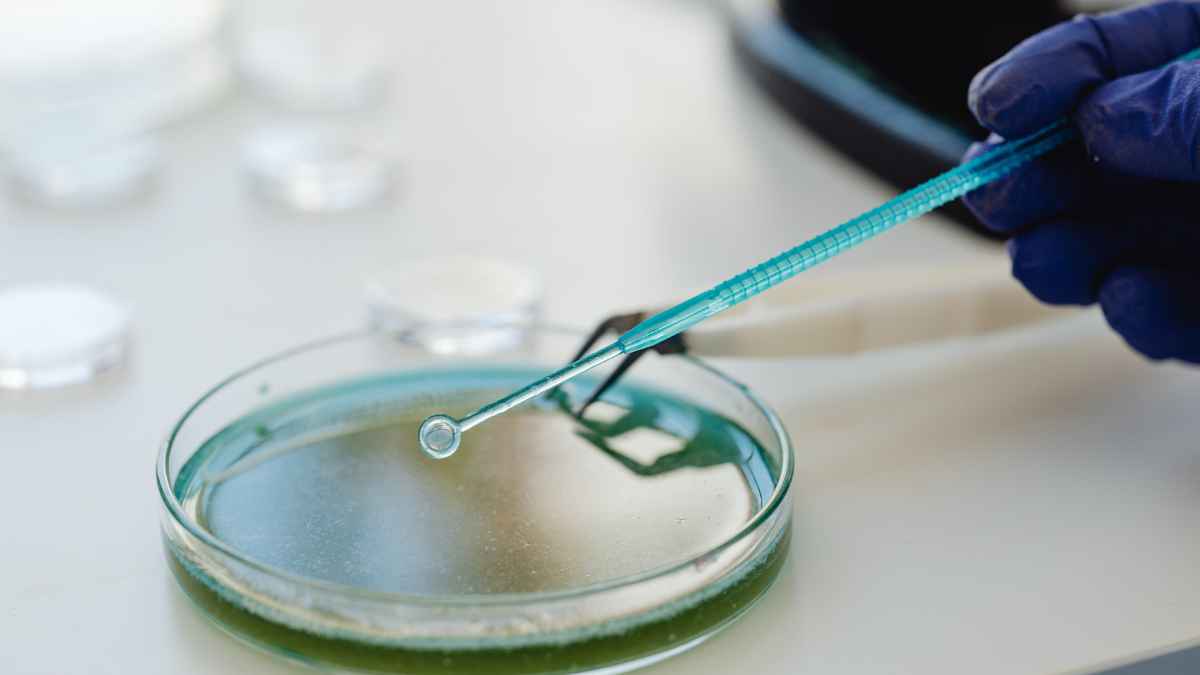
ImmunityBio SFDA engagement

Unit4, a leader in enterprise cloud applications for people-centric organizations, has closed the first half of 2025 with continued drive and momentum. Hosting its annual customer event, X4U, Unit4 saw growing demand from customers wanting to understand how its vision for self-driving ERP could help them modernize their IT systems. To meet that interest, Unit4 continues to invest in new technologies. Customer cloud migrations have continued at pace, with many now choosing to adopt Unit4’s Success4U service methodology to support a smooth transition.
Empowering Our Customers With Innovation
Unit4 recently announced the launch of Advanced Digital Agent, Ava, that streamlines ERP workflows with AI-driven orchestration and automation. In addition, Unit4’s Spring 2025 solution release introduced updates that simplify workflows and empower teams to deliver more impactful results. For example, Unit4’s Invoice Management Experience, powered by AI features like Invoice Data Capture (IDC) and the Accounting Prediction Service (APS). These features drastically improve accuracy and reduce processing time, with invoice coding accuracy increasing by up to 50% and processing times slashed by up to 30%.
Additionally, the new invoice follow-up screen, integrating Ava’s capabilities, makes tracking statuses simpler and more efficient. Combined, these improvements have been shown to cut supplier inquiries by up to 40%, freeing up teams to focus on what really matters.
Unit4’s resource request capabilities in ERPx make connecting the right talent with the right tasks faster and easier. Seamless communication between project managers and resource managers ensures projects stay on track and aligned with goals.
Celebrating 10 Years of Innovation With Crazy Lab Days
Unit4 proudly marks the 10th anniversary of Crazy Lab Days, its flagship internal innovation event that brings together employees from across regions and roles, empowering them to develop ideas over five months that address real customer challenges and deliver meaningful value.
From these submissions, the Product & Engineering leadership team selects the top five concepts to advance to the final stage, where they will be transformed into working prototypes. With strong backing from Unit4’s senior leadership, the most promising innovations are integrated into the company’s solutions portfolio.
Past successes include Ed the Manager (Smart Automation Services), Payroll Navigator, or AIMapping, which has revolutionized data discoverability.
Strengthening Customer Traction Across Broad Range of Industries
Unit4 closed the first half of the year with strong momentum in cloud migrations, new customer wins and customers who are live on Success4U. With 50% of engagements now using Success4U and more than 1,100 customers in the cloud, this showcases Unit4’s commitment to empowering customers to maximize their ERP investments and rapidly deliver value.
Unit4 continued to expand its North American customer base, with new customers such as Wedbush Securities, a leading financial services provider, headquartered in California.
Simon Paris, CEO, Unit4: “We understand how challenging it is for our customers to keep up with the pace of technology change, which is why we are committed enabling a smooth transition to the Cloud through our Success4U program. This helps minimize disruption and speeds the path to value, which speaking to customers at X4U, is a top priority. They are also excited to discuss our vision for self-driving ERP and how putting these cloud native foundations in place will enable them to embrace the latest innovations, including AI, when it’s right for their organization.”
Read Also: Veeva Tools Empower Boehringer Ingelheim